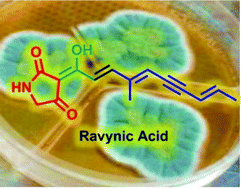

Ravynic acid, an antibiotic polyeneyne tetramic acid from Penicillium sp. elucidated through synthesis†
Abstract
A new antibiotic natural product, ravynic acid, has been isolated from a Penicillium sp. of fungus, collected from Ravensbourne National Park. The 3-acylpolyenyne tetramic acid structure was definitively elucidated via synthesis. Highlights of the synthetic method include the heat induced formation of the 3-acylphosphorane tetramic acid and a selective Wittig cross-coupling to efficiently prepare the natural compounds carbon skeleton. The natural compound was shown to inhibit the growth of Staphylococcus aureus down to concentrations of 2.5 µg mL−1.

- This article is part of the themed collection: Contemporary Synthetic Chemistry in Drug Discovery
Please wait while we load your content...
Please wait while we load your content...